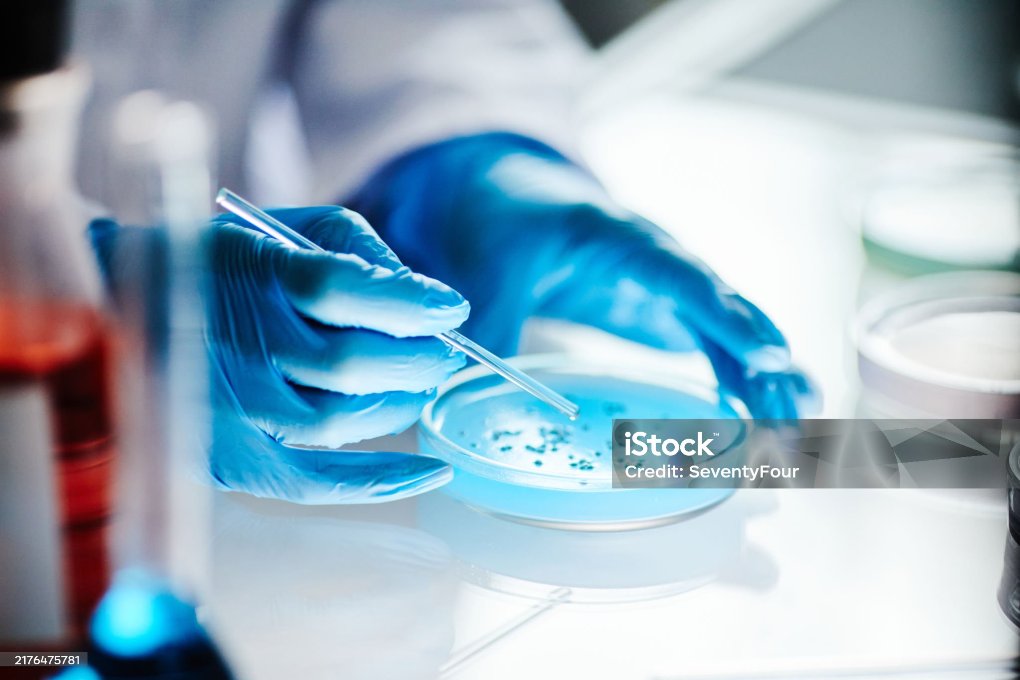
istockphoto-2176475781-2048x2048

В кожвендиспансере ЗКО состоялся День открытых дверей, когда каждый желающий смог получить бесплатную консультацию дерматовенерологов независимо от статуса застрахованности. Мероприятие приурочили ко Всемирному Дню профилактики ИППП - инфекций, передающихся половым путем (18 февраля).
Фото: istockphoto
Как рассказали специалисты областного кожвендиспансера, ежегодно во всем мире более 340 млн мужчин и женщин в возрасте 15-49 лет заболевают ИППП. Основной причиной их широкого распространения является рискованное поведение, беспорядочные половые связи, раннее начало половой жизни и половая близость в состоянии алкогольного опьянения. Эти инфекции, по словам медработников, могут повлечь за собой такие серьезные последствия, как герпес и сифилис, и повышать риск передачи ВИЧ в три или более раз. Передача ИППП от матери плоду может приводить к мертворождению, смерти малыша, рождению его с низкой массой тела, недоношенности, сепсису, пневмонии, неонатальному конъюнктивиту и врожденным дефектам.
- За последние три года в ЗКО наблюдается тенденция снижения заболеваемости инфекциями, передающимися половым путем. К примеру, в 2024-м, в сравнении с предыдущим годом, данный показатель снизился на 20,3% - с 267 до 213 случаев. Уровень заболеваемости сифилисом, по итогам прошлого года, снизился на 31,4% - всего в ЗКО было зарегистрировано 109 случаев (63 – среди мужчин и 46 - среди женщин). По возрастному составу наибольшее количество составляют западноказахстанцы в возрасте 30-44 лет, на долю 20-29 летних приходится 33% числа ИППП. Случаев сифилиса среди подростков 15-17 лет не зарегистрировано, не было и случаев врожденного сифилиса. За этот период было 27 случаев заболеваемости гонореей, что на 32,5% меньше, чем в 2023-м году. В половом аспекте отмечается явное преобладание мужчин, особенно с данным заболеванием в острой форме, что связано еще с более выраженными клиническими проявлениями. По возрастному составу 55,5% заболевших – это молодые 20-29 лет и 29,6% - 30-44 лет, - сообщила заведующая амбулаторно-поликлиническим отделением кожвендиспансера ЗКО Оралгуль Жантлеуова.
По словам специалистов, инфекции ППП при своевременном обращении к докторам вполне успешно излечиваются в настоящее время. В целях профилактики и снижения риска их инфицирования врачи областного кожвендиспансера советуют воздерживаться от случайных половых связей и при половых контактах обязательно использовать средства защиты.
- Важно знать, что на основании приказа Минздрава РК при обращении пациентов по поводу заболеваний дерматовенерологического профиля оказание специализированной медпомощи в амбулаторных условиях в рамках ГОБМП и в системе ОСМС осуществляется без направления из поликлиник. Достаточно просто позвонить к нам в регистратуру и записаться на прием (телефоны: 50-92-47, 50-01-91 и 87783289637). В Центре по профилактике ВИЧ-инфекции в дружественных кабинетах в рамках ГОБМП также проводится диагностика и лечение ИППП среди ключевых групп населения (работники коммерческого секса, мужчины, живущие с мужчинами, наркоманы). Внедрена доконтактная профилактика для групп населения, подвергающихся высокому риску инфицирования ВИЧ, в том числе имеющих ИППП и беспорядочные половые связи, - резюмировала О. Жантлеуова.
Галина Каренских,
zhaikpress.kz